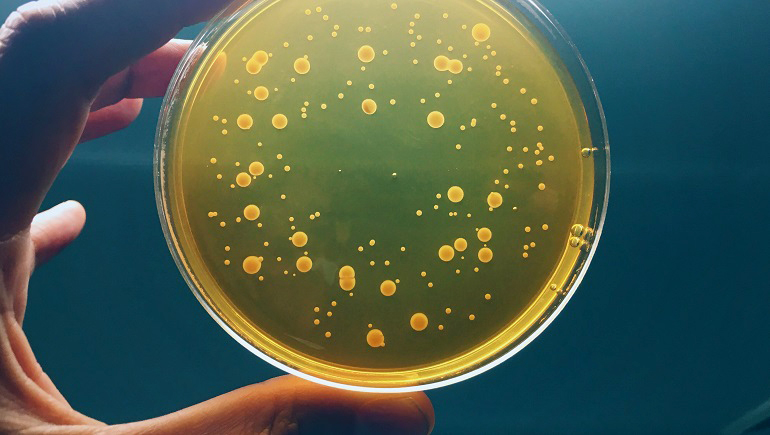

Микробные колонии: их характеристики и визуальные примеры

Раздел: Ключ к успеху